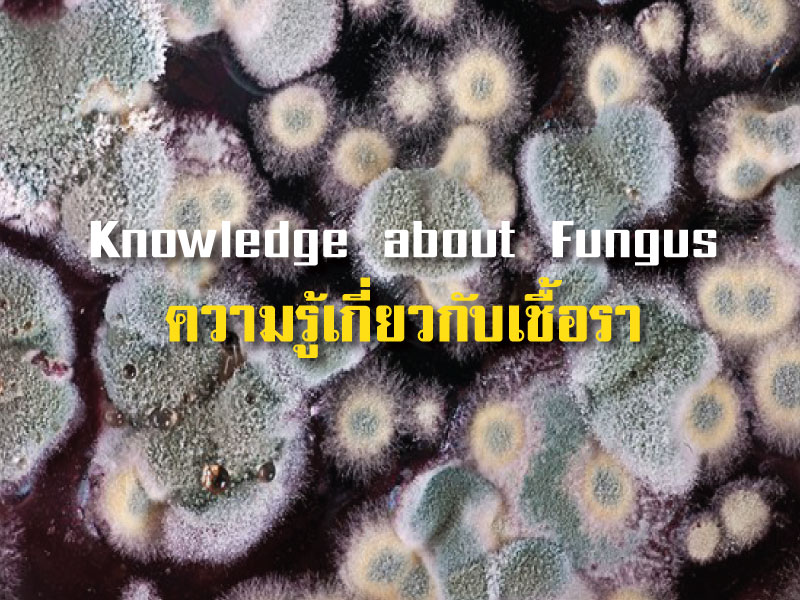
ความรู้เกี่ยวกับเชื้อรา (Knowledge about Fungus) ความรู้เกี่ยวกับเชื้อรา (Knowledge about Fungus)

ความรู้เกี่ยวกับเชื้อรา (Knowledge about Fungus)
เชื้อรา (Mold หรือ Fungus) เป็นสิ่งมีชีวิตที่อยู่ใกล้ชิดกับคนเรา อย่างที่เราเองก็คาดไม่ถึง เมื่อมองไปรอบๆ ไม่ว่าจะเป็นใน ดิน น้ำ อากาศ ต้นไม้ สัตว์ สิ่งไม่มีชีวิต หรือแม้กระทั่งภายในร่างกายของเรา เชื้อราจะมีอยู่ทุกๆ ที่ ถึงตอนนี้หลายๆ คนคงจะนึกภาพเชื้อราไปในทางที่ให้โทษมากกว่า เรามักจะคุ้นเคยกับภาพเส้นใยเชื้อราที่ขึ้นพองฟูตามขนมปังและเมล็ดพืชต่างๆ รวมทั้งโรคที่เกิดจากเชื้อรา เช่น โรคเชื้อราในหนังศีรษะ หรือ รังแค โรคน้ำกัดเท้า หรือ ฮ่องกงฟุต แต่ทราบหรือไม่ว่าเชื้อรายังมีบทบาทต่อเราในด้านอื่นๆ อีกมากมาย

เชื้อรา คือ จุลินทรีย์ชนิดหนึ่งที่ไม่มีคลอโรฟิลล์ จึงไม่สามารถสังเคราะห์แสงสร้างอาหารเองได้ ดํารงชีวิตได้ โดยการดูดซึมสารอาหาร จากการย่อยสลายซากสิ่งมีชีวิต และการอาศัยอาหารจากสิ่งมีชีวิตชนิดอื่น เชื้อราส่วนใหญ่เจริญได้ดีที่อุณหภูมิประมาณ 25-30 องศเซลเซียส เชื้อราเป็นพวกที่ต้องการออกซิเจนและชอบความเป็นกรด เชื้อราเดิมทีจัดอยู่ในอาณาจักรเดียวกับพืช ต่อมา นักวิทยาศาสตร์ได้ทําการศึกษาพบว่า มีคุณสมบัติต่างจากพืชและสัตว์ จึงจัดอาณาจักรใหม่เป็นอาณาจักรเห็ดรา โดยในปัจจุบันค้นพบ เชื้อรามากกว่า 1 แสนชนิด แต่ที่กระจายอยู่ทั่วโลกน่าจะมีมากกว่า 2 ล้านชนิด ลักษณะรูปร่างของเชื้อราเมื่อเจริญในอาหารจะมีลักษณะ ฟูคล้ายปุยฝ้าย ส่วนใหญ่สีขาว แต่บางทีมีสีสดหรือสีหม่นๆจนถึงดําซึ่งเป็นสีของสปอร์ โดยสีอ่อนแก่จะแสดงถึงการเจริญเติบโตเต็มที่ ของราบางชนิดด้วย ส่วนใหญ่สืบพันธุ์โดยการสร้างสปอร์ เชื้อราจะสร้างเส้นใย ถ้าแบบเส้นใยเล็กๆ มักเรียกว่า เชื้อรา แต่ถ้าเป็น แบบกลุ่มเส้นใย เรียกว่า เห็ด เส้นใยเชื้อราจะฝังตัวอยู่ในดิน ในพื้นไม้หรือแหล่งอาหารต่างๆ ที่เชื้อราเกาะอยู่ เชื้อราบางชนิด มีการแบ่งตัววัดความยาวได้มากถึง 1 กิโลเมตรต่อวัน และเส้นใยนี่เองที่เป็นตัวดูดซึมสารอาหารพร้อมทั้งปล่อยสารต่างๆออกมา ย่อยสลายสิ่งต่างๆ ที่เชื้อราเกาะอยู่ได้อย่างรวดเร็ว ทําให้เราเห็นว่า บางทีเพียงแค่หนึ่งคืนอาหารของเราก็เน่าเสียได้โดยง่าย แต่อย่างไร ก็ตามเชื้อราก็ทําลายได้ง่ายๆ เพียงแค่ฆ่าเชื้อแบบ พาสเจอร์ไรส์ แต่ก็ไม่ทําให้เชื้อราสูญพันธุ์ไปจากโลกนี้ง่ายๆ เพราะสปอร์ของเชื้อรา ทนความร้อนได้สูงมาก ส่วนใหญ่เรารู้จักโทษของเชื้อรากันเป็นอย่างดีจากโรคติดเชื้อที่เกิดจากเชื้อรา
โรคสำหรับเชื้อรา
ไม่ว่าจะเป็นโรคผิวหนัง กลาก เกลื้อน ภูมิแพ้ และเชื้อราบางชนิดยังสามารถสร้างสารพิษได้ เช่น สารอะฟลาทอกซิน เมื่อสารพิษนี้ เข้าไปสะสมในร่างกายในปริมาณที่มากเกินจะทําให้เกิดโรคเนื้อเยื่อในสมองอักเสบ และมะเร็งในตับ โดยสารพิษนี้มีความสามารถใน การทนต่อความร้อนได้ถึง 300 องศาเซลเซียส ซึ่งระดับความร้อนของการหุงต้ม ปรุงอาหารจะไม่สามารถทําลายสารพิษนี้ได้ จึงต้อง ป้องกันตนเองโดยเลือกอาหารที่ปลอดภัยจากเชื้อรา นอกจากนี้ เชื้อรายังเป็นตัวการในการทําให้อาหารต่างๆ เน่าเสียได้ง่ายขึ้น เนื่องจากเชื้อราสามารถเจริญในอาหารที่ค่อนข้างแห้ง หรือมีความเป็นกรดเล็กน้อยได้ และยังเป็นศัตรูตัวร้ายของเกษตรกรเช่นกัน เพราะโรคพืชส่วนใหญ่เกิดจากเชื้อรา ด้วยเหตุที่เชื้อราสามารถเจริญเติบโตได้ดีในสิ่งแวดล้อมหลากหลาย โดยเฉพาะในที่มี อินทรีย์วัตถุสูงๆ เชื้อราจึงมีประโยชน์ต่อระบบนิเวศในแง่ของการย่อยสลายซากสิ่งมีชีวิตต่างๆ ทําให้ระบบนิเวศเกิดความสมดุล นอกจากนั้น เชื้อรายังสามารถนํามาประยุกต์ใช้ให้เกิดประโยชน์ได้อย่างมากมาย เห็ด เป็นเชื้อราอีกชนิดหนึ่งที่เรารู้จักกันดี แต่น้อยคน ที่จะรู้จักว่าเห็ดเป็นเชื้อราชนิดหนึ่ง
สุดท้ายนี้ ความรู้เกี่ยวกับเชื้อรา หวังว่าคงจะเป็นประโยชน์กับทุกคนนะครับ และหากใครต้องการที่จะกำจัดเชื้อราในบ้านหรือสถานที่ต่างๆ ทาง Dr.ปลวก มีบริการกำจัดเชื้อรา ด้วยความเป็นมืออาชีพ จึงมั่นใจหายห่วงได้ครับ